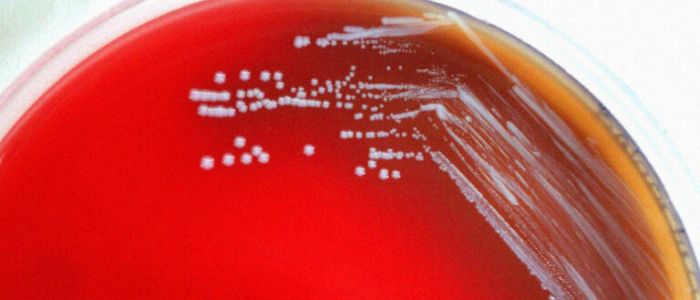
Тисячі заражених після витоку на китайському фармацевтичному заводі

Тисячі заражених після витоку на китайському фармацевтичному заводі
Тисячі людей на північному заході Китаю заразилися бактеріальним захворюванням після того, як витік минулого року на біофармацевтичному заводі викликав спалах, повідомляє CNN.
За повідомленнями місцевих ЗМІ, понад 3000 осіб в столиці провінції Ганьсу заразилися бруцельоз — захворюванням, яке зазвичай пов'язане з домашньою худобою, переносить бактерії бруцели.
Бруцельоз, також відомий як мальтійська або середземноморська лихоманка, може бути заражений при вживанні зараженої їжі або вдиханні бактерій. Симптоми включають головний біль, м'язові болі, лихоманку і втому. За даними CDC, деякі симптоми можуть зберігатися «на більш тривалий період часу». «Інші можуть ніколи не піти й не з'явитися знову».
Профіль зараження бактеріями сильно відрізняється від COVID, який, судячи з усього, з'явився в Китаї минулого року. Бруцела — це скоріше бактерія, ніж вірус, вона рідко буває смертельної й майже ніколи не передається від людини до людини. На щастя, під час цього спалаху не було зареєстровано жодного смертельного випадку.
В США були свої власні напади бруцельозу, які коштували тваринницької галузі мільярди доларів, щоб викорінити його серед великої рогатої худоби, особливо бізонів в районі Великого Єллоустоуну.
За даними місцевої влади в Ланьчжоу, робочі на фабриці не змогли продезінфікувати відпрацьований газ, і вітер поніс його в Ланьчжоуського науково-дослідний ветеринарний інститут, де в листопаді вперше було повідомлено про спалах.
За даними державного новинного сайту Xinhua, щонайменше 181 людина в інституті заразились на цю хворобу на ранньому етапі.
Влада відкликали ліцензії на виробництво вакцин, в тому числі дозволи на виробництво двох вакцин проти бруцельозу, на заводі в січні, повідомляє CNN. Згідно з публічними вибаченнями, принесеним заводом, вісім осіб, визнаних винними в цьому заході, були «строго покарані».
Джерела: CNN



